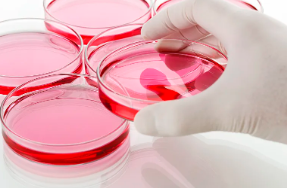
image.png

國內哪家公司干細胞技術領先?效果如何評估?
2024-11-01 11:59:39 來源: 小編 咨詢醫(yī)生
本文將深入探討國內干細胞技術領域的領先企業(yè),以及如何評估其技術效果。
干細胞技術作為現(xiàn)**物科技的重要分支,近年來在我國得到了迅速發(fā)展。在眾多從事干細胞研究的企業(yè)中,以下幾家公司在干細胞技術方面具有較高的領先地位。
一、北京干細胞庫
北京干細胞庫是我國最早從事干細胞研究的企業(yè)之一,擁有國際先進的干細胞技術。該公司在干細胞制備、保存和臨床應用方面具有豐富經驗,已成功制備并保存了數(shù)千份干細胞。北京干細胞庫的技術效果評估主要體現(xiàn)在以下幾個方面:
1.干細胞制備:采用國際先進的分離、純化和培養(yǎng)技術,確保干細胞的活性和純度。
2.干細胞保存:采用先進的凍存技術,保證干細胞的長期保存和活性。
3.臨床應用:在多種疾病治療中取得了顯著效果,如神經系統(tǒng)疾病、心血管疾病等。
二、上海干細胞科技有限公司
上海干細胞科技有限公司是一家專注于干細胞技術研究和臨床轉化的企業(yè)。該公司在干細胞制備、臨床應用和產學研合作方面具有較高水平。其技術效果評估如下:
1.干細胞制備:采用國際先進的制備技術,確保干細胞的活性和純度。
2.臨床應用:已開展多項干細胞治療研究,如骨關節(jié)疾病、肝硬化等,取得了良好效果。
3.產學研合作:與多家醫(yī)療機構和研究機構建立合作關系,共同推動干細胞技術臨床轉化。
三、深圳賽爾生物科技有限公司
深圳賽爾生物科技有限公司是一家致力于干細胞技術研究和產業(yè)化的企業(yè)。該公司在干細胞制備、保存和臨床應用方面具有較高水平。其技術效果評估如下:
1.干細胞制備:采用先進的制備技術,確保干細胞的活性和純度。
2.干細胞保存:采用先進的凍存技術,保證干細胞的長期保存和活性。
3.臨床應用:已開展多項干細胞治療研究,如神經系統(tǒng)疾病、心血管疾病等,取得了顯著效果。
四、如何評估干細胞技術效果?
評估干細胞技術效果,可以從以下幾個方面進行:
1.干細胞制備:制備的干細胞活性和純度是評估技術效果的關鍵指標。
2.干細胞保存:保存時間、活性保持程度等是評估干細胞保存技術效果的重要指標。
3.臨床應用:治療效果、安全性、患者滿意度等是評估干細胞臨床應用效果的重要指標。
4.產學研合作:與醫(yī)療機構和研究機構的合作程度,以及研究成果的轉化速度,也是評估干細胞技術效果的重要參考。
總之,國內干細胞技術領域,北京干細胞庫、上海干細胞科技有限公司和深圳賽爾生物科技有限公司等企業(yè)具有較高領先地位。在評估其技術效果時,可以從制備、保存、臨床應用和產學研合作等多個方面進行綜合分析。隨著干細胞技術的不斷發(fā)展和應用,未來我國在干細胞領域有望取得更多突破。
- 2024-11-09干細胞再生技術治療脫發(fā)效果好嗎,作用原理是什么
- 2024-11-11干細胞再生療法如何治療肌腱病,哪種療法更有效
- 2024-10-23禪城醫(yī)院干細胞中心治療技術領先嗎?成功率多高?
- 2024-10-29博鰲干細胞治療臨床效果有哪些優(yōu)勢與不足?如何評估其安全性?
- 2024-11-08安徽蚌埠捐贈干細胞機構有哪些?
- 2024-10-28造血干細胞捐獻后如何恢復身體?捐獻造血干細胞有哪些影響?
- 2024-08-10干細胞面部美容真的有用嗎
- 2024-09-14西安干細胞注射價格表,西安哪里可以打干細胞
- 2024-09-18干細胞治療臨床了嗎,需要多少時間
- 2024-09-16干細胞療法的壞處和好處有哪些
- 2024-07-30臍帶間充質干細胞存儲費用,臍帶間充質干細胞需要配型嗎
- 2024-09-10免疫NK干細胞療法怎么樣,多少錢一個療程
- 2024-08-23臍帶干細胞怎樣存儲,存儲方法與注意事項介紹
- 2024-09-15人參干細胞的作用和功效,人參植物干細胞的用途
- 2024-09-26干細胞研究現(xiàn)狀如何展開,未來治療潛力有多大
- 2024-09-21干細胞填淚溝效果好嗎,可以保持多久
- 2024-09-22干細胞療法騙局曝光,干細胞療法可靠嗎
- 2024-08-10干細胞面部美容真的有用嗎
